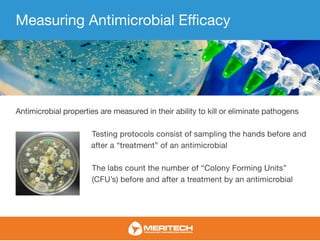
Measuring Antimicrobial Efficacy
Antimicrobial properties are measured in their ability to kill or eliminate pathogens
Testing protocols consist of sampling the hands before and
after a “treatment” of an antimicrobial
The labs count the number of “Colony Forming Units”
(CFU’s) before and after a treatment by an antimicrobial

The document defines key terms related to microbiology, including infection, microbe, pathogen, bacteria, virus, fungi, and parasite. It explains that an infection occurs when a pathogen colonizes and multiplies within a host, interfering with the host's normal functioning. Microbes, pathogens, bacteria, viruses, fungi and parasites are all microorganisms that can cause infection. The document also provides definitions of antimicrobial, which destroys or inhibits microorganisms, and describes how antimicrobial efficacy is measured based on reductions in colony forming units after treatment. Log reductions are used as a unit of measurement, with higher log reductions corresponding to greater percent reductions in bacteria.